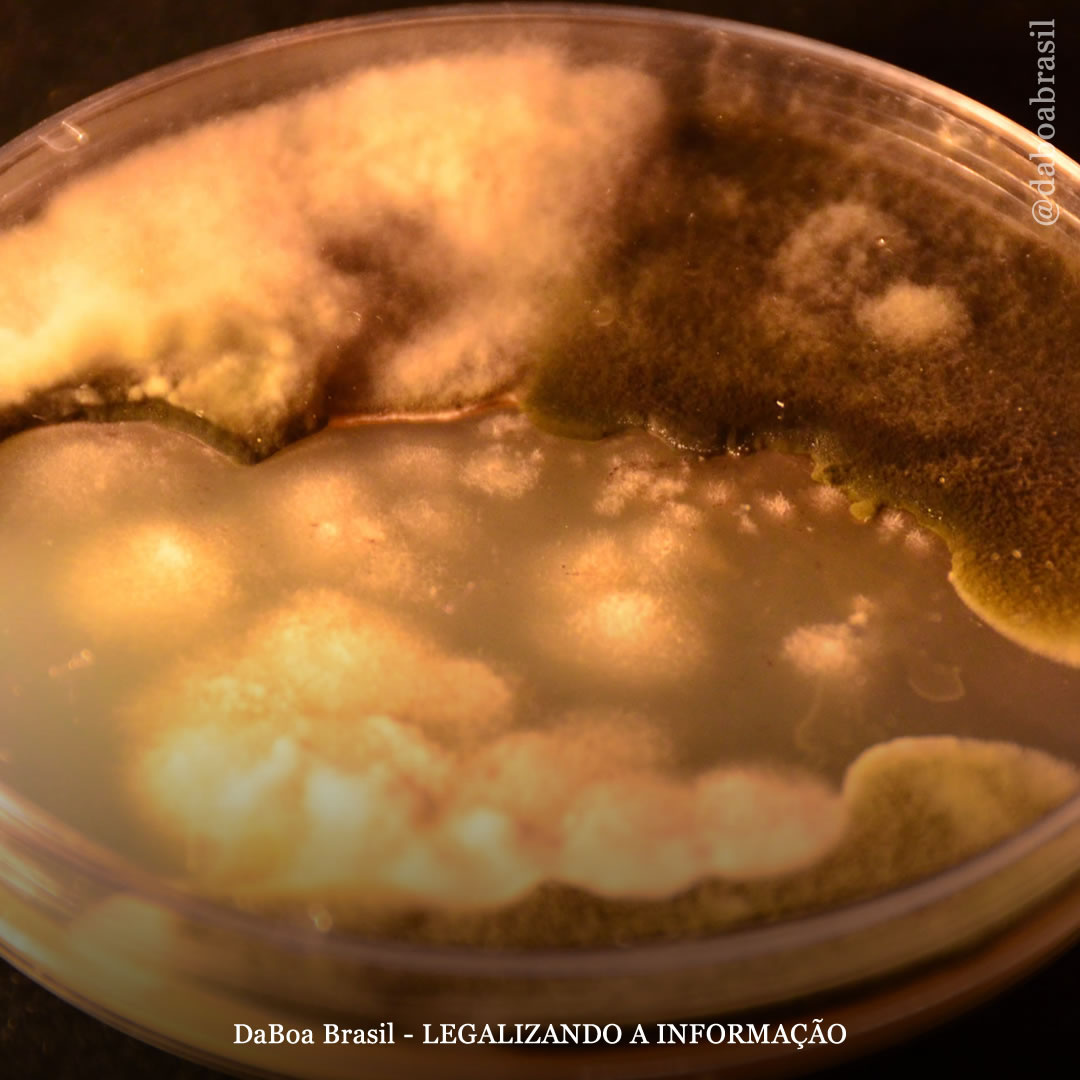
Dicas de cultivo: microrganismos benéficos – Trichodermas

Dicas de cultivo: como germinar sementes de maconha
No post de hoje você descobrirá como germinar sementes de maconha passo a passo usando diferentes métodos. Todos são válidos, o importante é germinar suas sementes. Em seguida, cada cultivador escolherá o sistema com o qual se sente mais confortável ou com o qual...
Dicas de cultivo: as chaves para a melhor colheita utilizando a técnica SCROG
SCROG (Screen of Green) é uma técnica de alto desempenho amplamente utilizada tanto no cultivo indoor (interno) quanto no outdoor (externo). Consiste em cobrir uma área de cultivo com poucas plantas. Para manter todos os galhos na mesma altura, uma rede, tela ou...
Dicas de cultivo: guano de morcego, um dos fertilizantes mais utilizados
Quando falamos em cultivo orgânico de maconha, existem dois dos fertilizantes mais usados no mundo. Húmus de minhoca para um crescimento rápido e saudável e guano de morcego para uma floração exuberante e buds mais saborosos. Além disso, são muito baratos e se...
Dicas de cultivo: como evitar o ataque de fungos no cultivo indoor
Os fungos no cultivo de maconha são muito comuns. Só é necessário que sejam dadas as condições adequadas, para que em questão de dias tenha suas plantas afetadas. Na melhor das hipóteses, sofrerá apenas alguma perda de uma folha ou bud. Na pior das hipóteses, poderá...
Dicas de cultivo: os benefícios do cultivo associado da hortelã com a maconha
O cultivo de várias espécies de plantas nas proximidades pode prevenir pragas e enriquecer o solo. A hortelã é uma ótima planta para associar ao seu cultivo de cannabis e um ingrediente comum em receitas e óleos essenciais. No post de hoje, você vai saber tudo que...
Dicas de cultivo: passos a seguir para fazer uma planta-mãe de maconha
Uma planta mãe (ou madre) de maconha é aquela que nos fornece mudas. Normalmente, são faladas como plantas selecionadas entre várias e que se destacam em vários aspectos positivos. E como um clone é uma cópia exata de sua mãe, não adianta ter uma planta que não seja...
Dicas de cultivo: como fazer um sistema de irrigação por gotejamento para plantas de maconha
A irrigação por gotejamento pode parecer cara ou complicada de instalar, mas não precisa ser. Neste artigo, vamos orientá-lo através de duas maneiras de fazer um sistema de irrigação por gotejamento para ajudá-lo a reduzir o trabalho físico e cultivar plantas de...
Dicas de cultivo: tudo o que você precisa saber sobre a pré-floração (fase de transição)
Chamamos de pré-floração, ou fase de transição, o período que decorre entre o final da fase de crescimento e o início da fase de floração. Esta é uma fase curta, geralmente entre 10-15 dias, embora dependa em grande parte da variedade cultivada. Nessa fase também...
Dicas de cultivo: a importância de um bom sistema de ventilação no cultivo indoor
Se você planeja iniciar um cultivo de maconha em ambiente fechado, sempre precisa ter clareza sobre o básico. Com ele será muito fácil para as plantas terem boas condições de crescimento. Caso contrário, as plantas podem ser condenadas a uma vida cheia de...
Dicas de cultivo: superfertilização em plantas de maconha, como detectar e resolver
Uma superfertilização em um cultivo de maconha é sempre um revés. É algo que qualquer cultivador sofreu em algum momento, e nem sempre está relacionado à inexperiência. A causa é sempre a mesma, um excesso de nutrientes que a planta não é capaz de assimilar, o que na...
Dicas de cultivo: como podar as raízes de suas plantas de maconha
Embora raras, as raízes das plantas também podem ser podadas. E em certos casos, é preciso fazer uma boa poda de raízes para garantir um bom desenvolvimento da planta. As principais funções das raízes são a absorção de água e sais minerais do solo e depois...
Dicas de cultivo: microrganismos benéficos – Trichodermas
Você sabe o que são trichodermas (ou tricodermas) e quais as vantagens de usá-los no cultivo de maconha? Vamos explicar isso no post de hoje. Microrganismos e bactérias benéficas do solo A vida de um substrato, ou seja, os microrganismos que nele vivem, são seus...
Dicas de cultivo: é possível fazer clones de variedades autoflorescentes?
Uma pergunta recorrente entre os novos cultivadores é se existe a possibilidade de tirar clones de plantas autoflorescentes (ou automáticas). E a resposta é ambígua: SIM e NÃO. Mas no post de hoje vamos explicar o motivo dessa resposta para que quem tiver dúvidas...
Dicas de cultivo: 5 conselhos importantes para iniciar um cultivo indoor
O cultivo indoor é mais propício quando os dias quentes estão acabando, pois a luz das lâmpadas aumenta a temperatura da área de cultivo. Uma vez que os dias mais quentes do ano já passaram, muitos cultivadores sabem que é hora de começar a cultivar dentro de casa. A...
Dicas de cultivo: proteja suas plantas contra o fungo Botrytis
Os cultivos de maconha, principalmente ao ar livre, estão expostos a ataques de fungos, especialmente em locais úmidos e chuvosos. E entre todos eles, o fungo botrytis é, sem dúvida, um dos piores que pode atacar as plantas na fase de floração. É a causa de inúmeras...